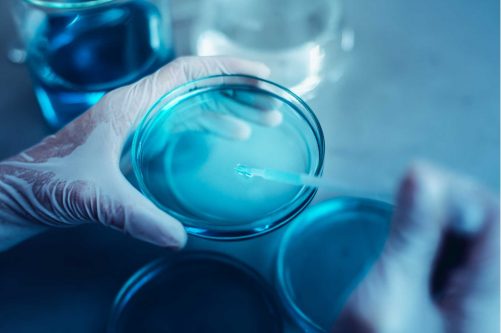
儿童玩具微生物检测

玩具微生物检测是保障儿童产品安全与质量的关键环节。在生产、运输和使用过程中,这类产品容易受到微生物污染,若缺乏有效检测,可能引发质量问题及儿童健康风险。通过严格的微生物检测,可有效降低风险,确保产品安全与合规。
根据美国消费品安全委员会(CPSC)的相关要求,进入美国市场的玩具及儿童产品必须符合安全法规,包括微生物风险的有效管控。
支持法规
| 玩具微生物法规 | 测试方法 |
| 美国ASTM F963-23第4.3.6.3/8.4.1节 | 美国药典 USP第61.62章 FDA 细菌分析手册 |
| 美国ASTM F963-23第4.3.6.4/8.4.2节 | 美国药典 USP第51章 |
需测试产品类别
- 化妆品:粉底液、眼线、口红、身体彩绘
- 液体:泡泡水/泡泡机、液体沙漏/油滴玩具
- 膏体:玩具史莱姆、彩泥/橡皮泥
- 油灰:太空泥/超轻油灰、仿真修补油灰玩具
- 凝胶:水凝珠/水精灵、水晶泥/透明史莱姆
- 粉末:彩色沙/彩绘沙画、手工帖土粉/石膏粉
- 禽类羽毛:羽毛头饰/发饰、羽毛面饰/眼罩
CMA Testing 现已加入亚马逊TIC指定的DV(Direct Validation)直接验证合作实验室体系,不仅为客户提供专业的微生物检测服务,还能帮助产品顺利满足CPSC法规及亚马逊平台的合规要求,为企业开拓美国市场保驾护航。